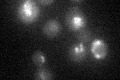
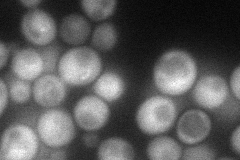

View description
Subunit of the condensin complex; required for establishment and maintenance of chromosome condensation, chromosome segregation, chromatin binding of condensin, tRNA gene clustering at the nucleolus, and silencing at the mating type locus
Localization:
Intensity:
Fold change:
Significance:
-
C’ GFP library in SD
nucleus21.83 -
N' NOP1pr-GFP in SD
cytosol,punctate63.0491 -
N' TEF2pr-mCherry in SD

cytosol61.733 -
N' NATIVEpr-GFP in SD

punctate,nucleus22.9535 -
N' TEF2pr-VC and Cyto-VN in SD

cytosol42.9772 -
C’ GFP library in SD+DTT

technical problem0N/AYes -
C’ GFP library in SD+H2O2

nucleus25.961.18No -
C’ GFP library in Starvation Media

nucleus22.51.03No -
C’ GFP library on the background of Pup2-DaMP

N/A -
C’ GFP library on the background of CCT mutant

N/A0N/AYes
